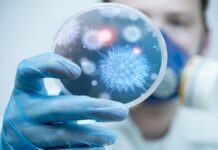
На Вінниччині 954 хворих гострими кишковими інфекціями та 84 хворих COVID-19

Мітка: епідситуація
У Вінницькій області зростає рівень захворюваності на грип та ГРВІ
У Вінницькому медіацентрі відбувся брифінг генерального директора Вінницького обласного центру контролю та профілактики хвороб Ігоря Матковського. Під час заходу фахівець повідомив про погіршення епідеміологічної...
На Вінниччині зросла захворюваність на туберкульоз: Куди звертатись для обстеження
Напередодні Всеукраїнського дня боротьби з туберкульозом у приміщенні офіційного медіацентру обласної військової адміністрації відбувся брифінг, на якому виступила керівник інформаційно-аналітичного відділу НКП "Вінницький обласний...
Спалах гепатиту А на Вінниччині стали відомі подробиці
У Вінниці відбувся брифінг заступниці директорки Департаменту охорони здоров'я та реабілітації ОВА Тетяни Бондаренко. Зокрема, посадовиця розповіла, про ситуацію в області з захворюванням на вірусний...
На Вінниччині 954 хворих гострими кишковими інфекціями та 84 хворих COVID-19
Про Санітарно-епідемічну ситуацію в області, гострі кишкові інфекції, грип та ГРВІ, COVID-19, станом на 16 червня 2022, повідомив Олег Лук’янович, начальник відділу комунікації та...
У Вінниці 649 нових хворих на COVID-19 за добу
У місті стрімко зростає рівень захворюваності на COVID-19. За останню добу у Вінниці зафіксували 649 нових підтверджених випадків цієї хвороби. Завантаженість ліжкового фонду лікарень...
У Вінниці фіксують зростання захворюваності на COVID-19
Зросла кількість хворих, які перебувають на амбулаторному лікуванні, це 3108 вінничан.
У Вінницькій міськраді скасували рішення про перехід на онлайн навчання вінницьких шкіл
У зв'язку з необхідністю додаткового опрацювання рішення комісії"
Завтра всі школи Вінниці переходять в режим онлайн роботи
За даними департаменту охорони здоров’я міської ради, на стаціонарне лікування до Вінницької обласної дитячої клінічної лікарні в середньому щодня госпіталізують 40 дітей, до обласної дитячої інфекційної лікарні – 18 дітей.